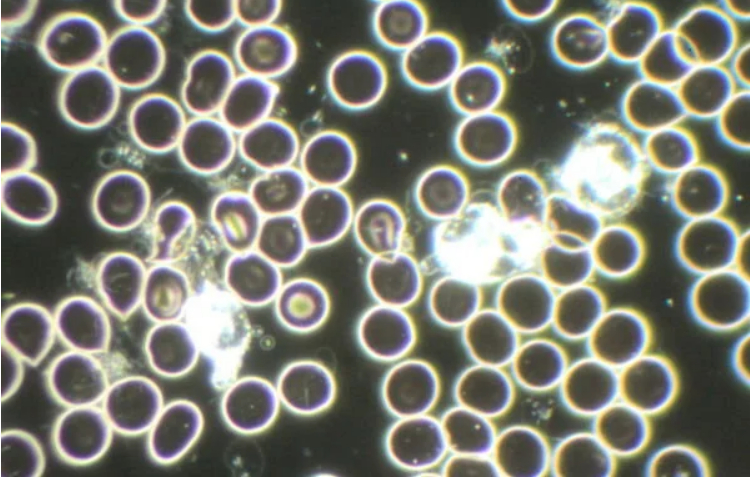
Live Blood Analysis

Our Cupping Services
All services are non-medical and complementary, intended to support your personal wellness journey:

Dry Cupping + Massage
45 minute session with unlimited cups.
R300

Wet Cupping
Unlimited Cups
R450
Live Blood Analysis
R650
